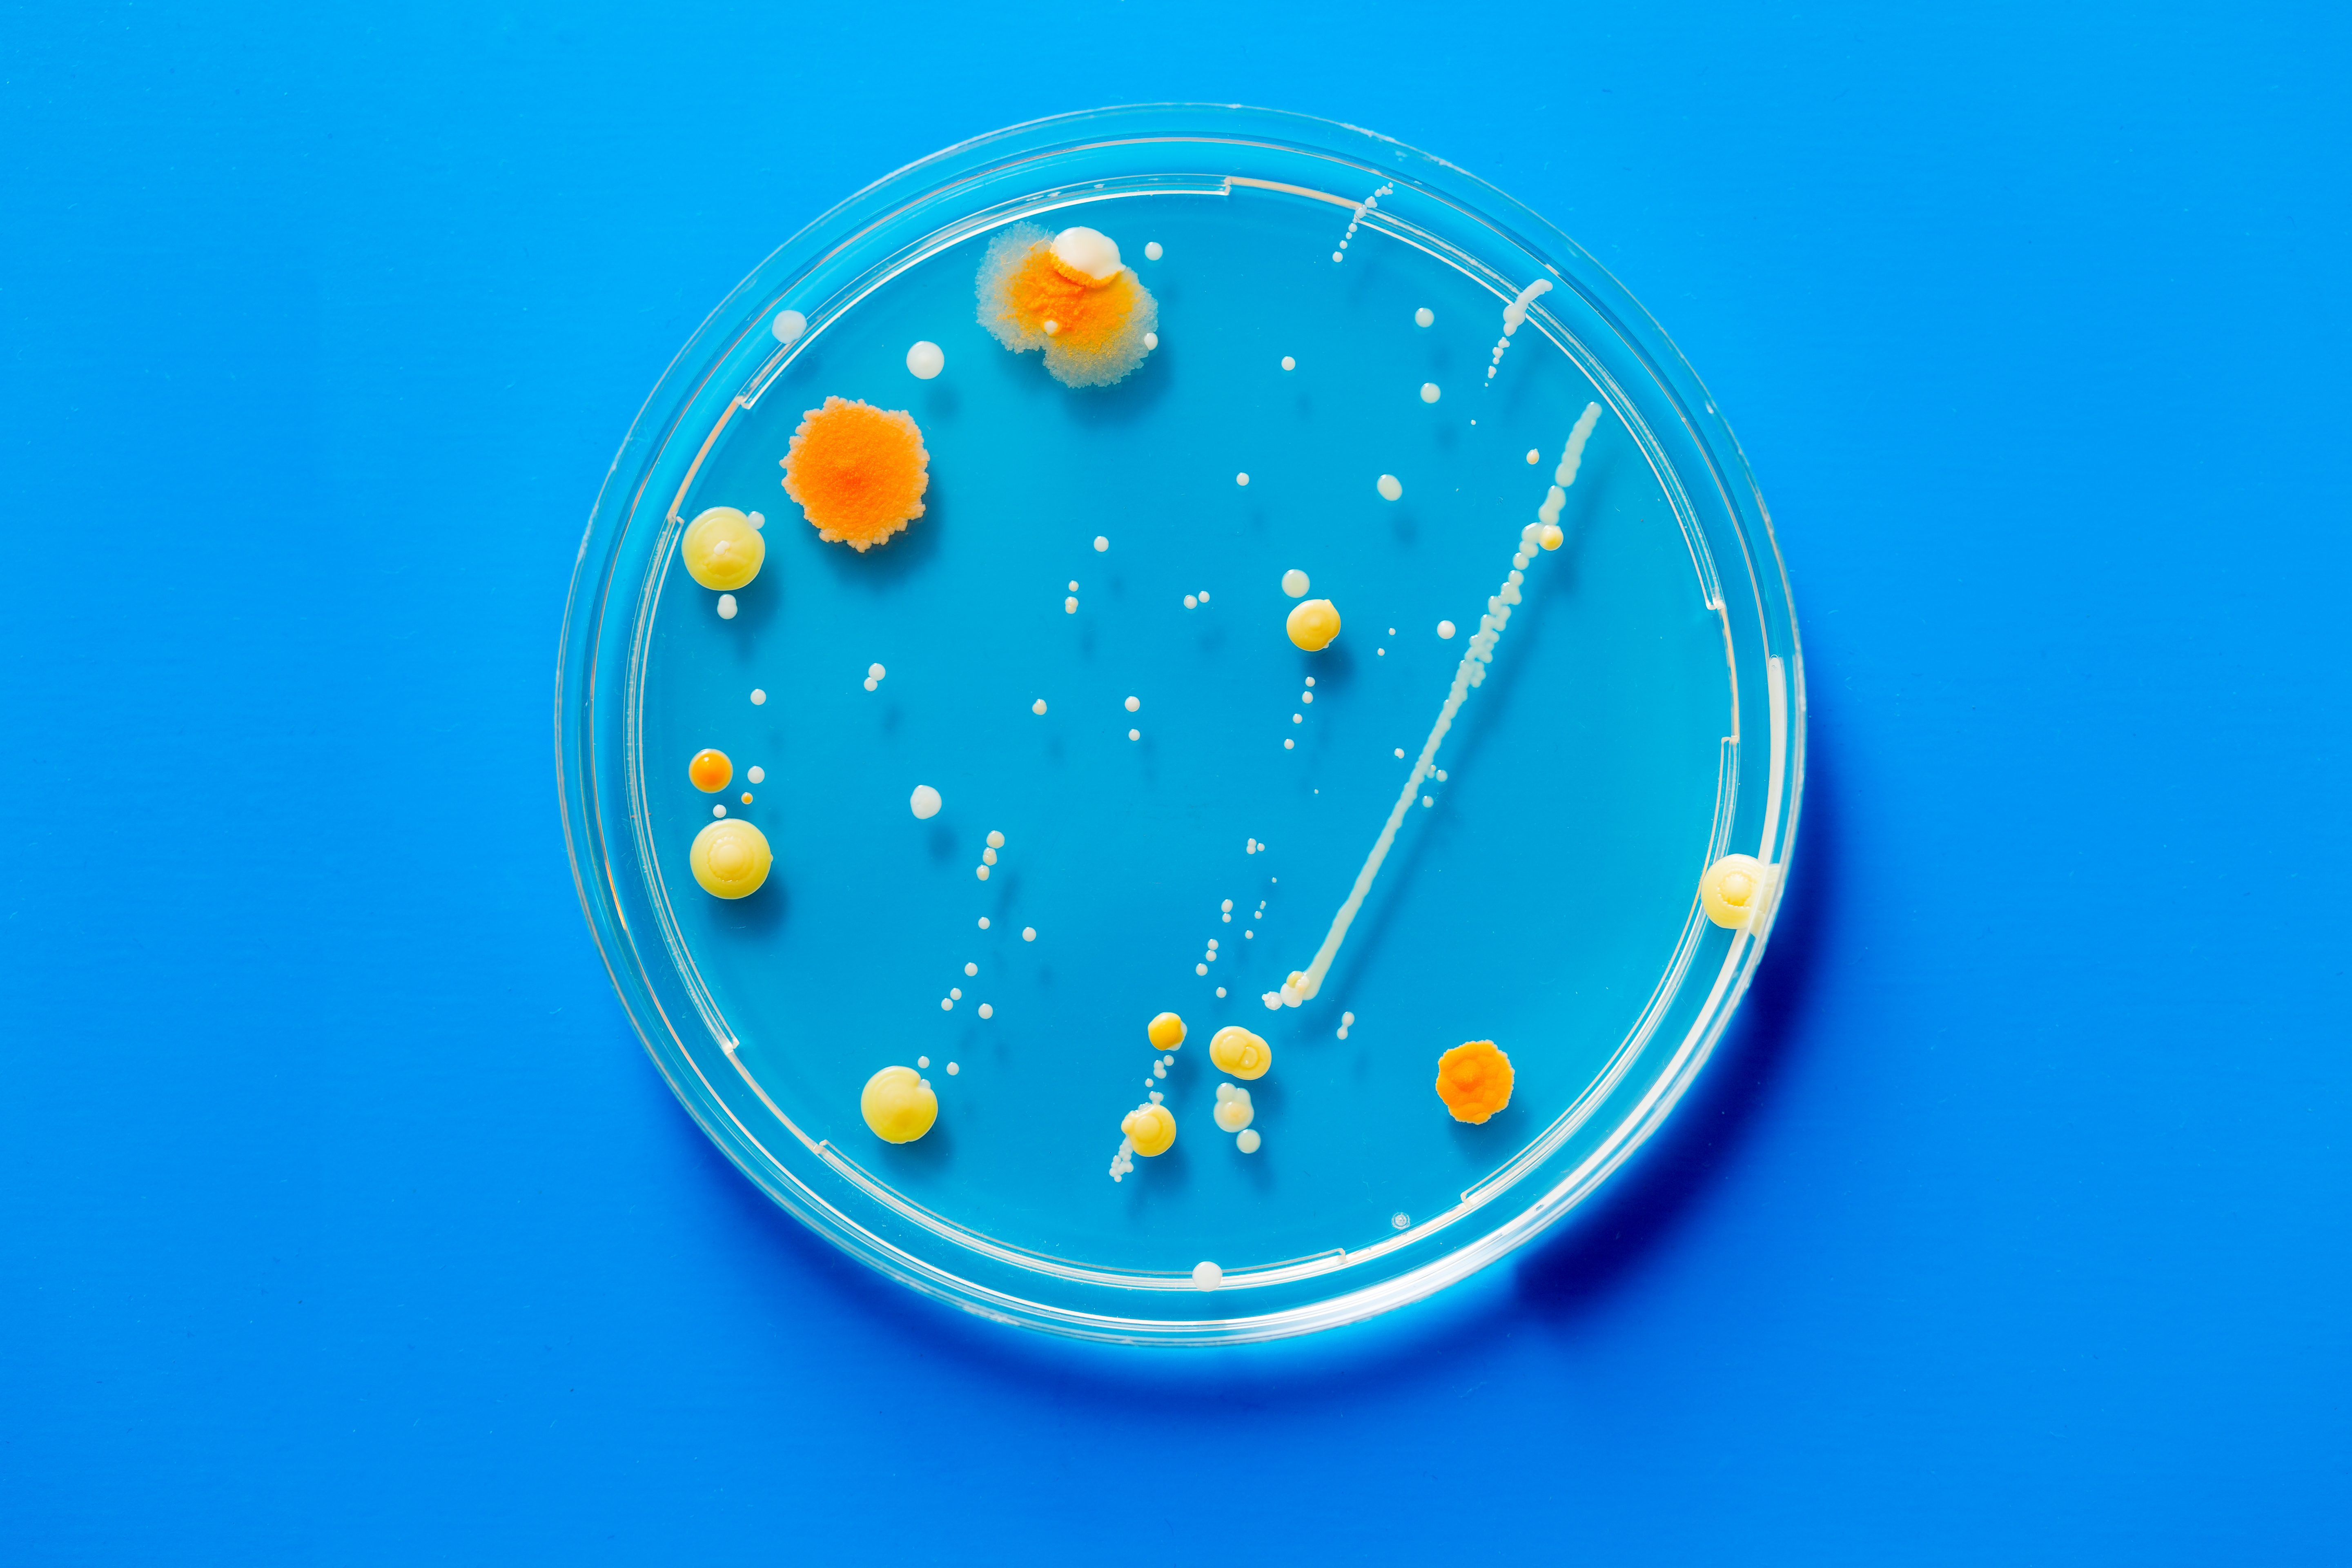

The North of England is home to some 15 million people. This makes up almost a quarter of the UK’s total population, and includes a mesh of proud local identities.
Compared to the rest of the UK, however, there is a persistent gap in GVA (gross value added) per capita and productivity performance. Analysis by the Treasury claimed that if the North’s economy grew as quickly as the UK average to 2030, its economic output would be £37 billion higher in real terms. There’s huge potential in North, but it needs the right support to unlock it.
The Northern Powerhouse Partnership is a business-led organisation aiming to do just that. In a new report, Powerhouse 2050: Transforming the North, it explores four areas of the economy, originally identified in the Northern Powerhouse Independent Economic Review, where the North has the potential to be a world leader within the next 33 years.
Given the right cooperation between business, university and government investment, these four sectors could create 850,000 more jobs and contribute an extra £100 billion to the UK economy by 2050.

New extra large press starts production at Nissan Sunderland, via Nissan Europe Newsroom
Advanced manufacturing and materials
The North has a strong history in manufacturing, from traditional steel production in Sheffield to shipbuilding in Hull. The region is currently home to several car manufacturing plants, including Vauxhall, Jaguar Land Rover and Nissan.
Building on this pedigree, the North’s real strengths lie in its ability to improve processes and productivity, as well as the development of new products.
Two key areas where it could be a world leader heading into 2050, are new lightweight and 2D materials, as well as high-precision engineering. Close connections between research institutions and manufacturing industries will help provide businesses in the region with access to cutting edge technology and the highly-skilled workforce needed to operate it.

Siemens and Drax engineers worked together to upgrade turbines at Drax Power Station. The five-year, £100m project was completed in 2012 [find out more]
Energy
The North has a long history of powering the UK and today still generates 41% of England’s electricity. Building on this strength in the field, the region has the potential to evolve into a world leader in the modern, low-carbon energy sector, through the repurposing of existing infrastructure, such as Drax Power Station’s transition from coal to biomass fuel.
“The North is uniquely placed to deliver the UK’s energy needs,” said Drax Power CEO Andy Koss. “There are huge opportunities for us as a region – not just in terms of potential jobs and the economic benefits, but also the positive environmental impacts associated with decarbonisation.”
Electricity generation, storage and low carbon technologies including nuclear, offshore wind and bioenergy are already well established in the North. However, there are also opportunities to re-use existing infrastructure, such as ‘greening’ the gas grid in Leeds by converting it to low carbon hydrogen.

Digital
The digital and tech sectors are often seen as a major driver for well-paid jobs that can drive national productivity and the wider economy. And while London remains the central hub for venture capital funding and high-profile startups, a report by Tech Nation found almost 70% of total investment in tech went to companies outside the capital in 2016.
This includes £78 million raised by Manchester tech businesses and £61 million invested in Sheffield companies. In fact, the wider digital sector, from adtech to fintech, now employs 168,671 people across city clusters in the North.
This is a strong base from which to grow the region’s tech and digital scene, which will be supported by initiatives such as the £400 million Northern Powerhouse Investment Fund and the £30 million for the region’s new National Innovation Centre for Data.

Health innovation
The North has long-established strengths in fields such as life sciences, medical technologies and devices. These include pharmaceutical and medical device manufacturing hubs across the region.
What makes the UK unique in the health innovation space is its ability to leverage the National Health Service as an asset for research, innovation and in developing new models of healthcare delivery – and the North is no different. This collaboration can allow companies and institutions in the field to sit at the forefront of implementing and developing treatments, medicines and devices for the 21st century.
The future of health innovation will be closely connected to tech fields of big data and AI and these, along with other types of research will require close collaboration between businesses, the NHS and the regions’ universities.
Within the relatively small UK, the North may still be a small part, often eclipsed by the country’s capital. But as the report shows, there is not only huge potential yet to be realised, but a strong history on which to build.















 Homes that power themselves
Homes that power themselves
 Bigger, more efficient batteries
Bigger, more efficient batteries